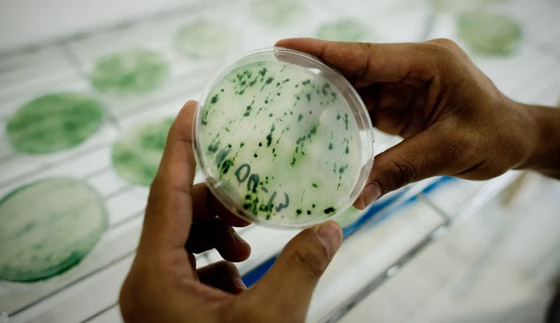
أفضل من اللحوم.. طحالب

توصل بحث علمي جديد إلى أن اتباع نظام غذائي يومي يتضمن الطحالب الخضراء المزرقة التي تعرف باسم "سبيرولينا"، يمكن أن يعزز الصحة ويبطئ تغير المناخ. وتعتبر طحالب "سبيرولينا" غذاءً خارقا لمحتواها الغني بالبروتين والحديد والأحماض الدهنية الأساسية.
وبالمقارنة مع اللحم البقري، تعتبر "سبيرولينا" خيارا غذائيا صحيا مميزا، كما أنها تعد بديلا مستداما للحوم كونها تترك بصمة بيئية أصغر مقارنة بالمنتجات الحيوانية التي ينجم عن الحصول عليها إطلاق كميات كبيرة من غاز الميثان.
- "أرقام مرعبة: يتطلب إنتاج كيلوغرام واحد من اللحم البقري 1450 لترا من الماء و340 مترا مربعا من الأراضي الخصبة إنتاج كيلوغرام واحد من لحم البقر يطلق 100 كيلوغرام من الميثان".
النبتة السحرية
يقترح مؤلفو الدراسة من كلية الاستدامة البيئية في جامعة رايشمان الإسرائيلية "سبيرولينا" بديلا للحوم. وأشار الباحثون في الدراسة التي نشرت نتائجها في مجلة "التكنولوجيا الحيوية البحرية"، إلى أن "سبيرولينا" ذاتية التغذية، تعتمد على التمثيل الضوئي وثاني أكسيد الكربون للحصول على الطاقة. ووفق الباحثين فإن إنتاج هذه الطحالب التي تزرع في أيسلندا، ستساعد في إخراج غازات الدفيئة من الغلاف الجوي، وتقليل آثار تغير المناخ.

وعلّق المؤلف المشارك في الدراسة آساف تزاكور قائلا: "يمكن أن يسير الأمن الغذائي، وتخفيف آثار تغير المناخ، والتكيف مع تغير البيئة جنبا إلى جنب. كل ما يجب على المستهلكين فعله هو تبني القليل من سبيرولينا الأيسلندية في وجباتهم الغذائية بدلا من لحم البقر". وأضاف تزاكور: "إنه صحي أكثر من اللحم ويوفر الاستدامة البيئية. أي تغيير نرغب في رؤيته في العالم يجب أن يتجلى في خياراتنا الغذائية".

